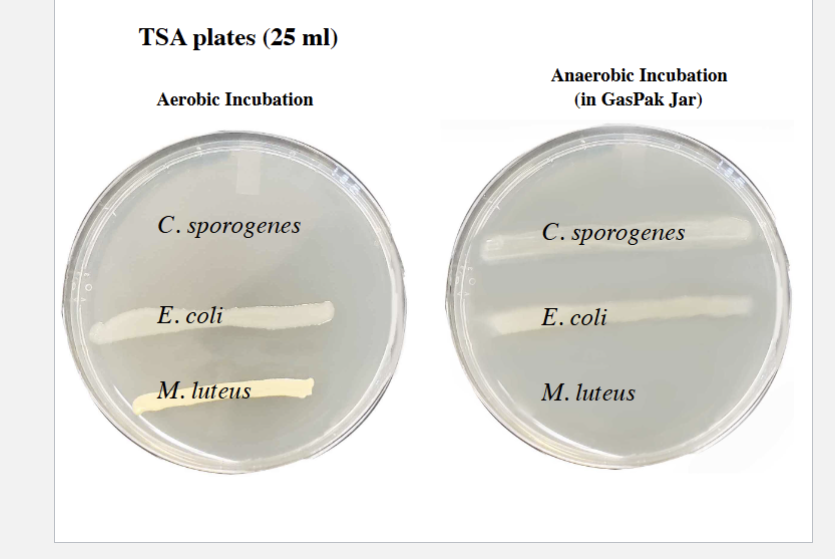
<p>LOOK AND KNOW, it goes with other stuff</p><p></p>
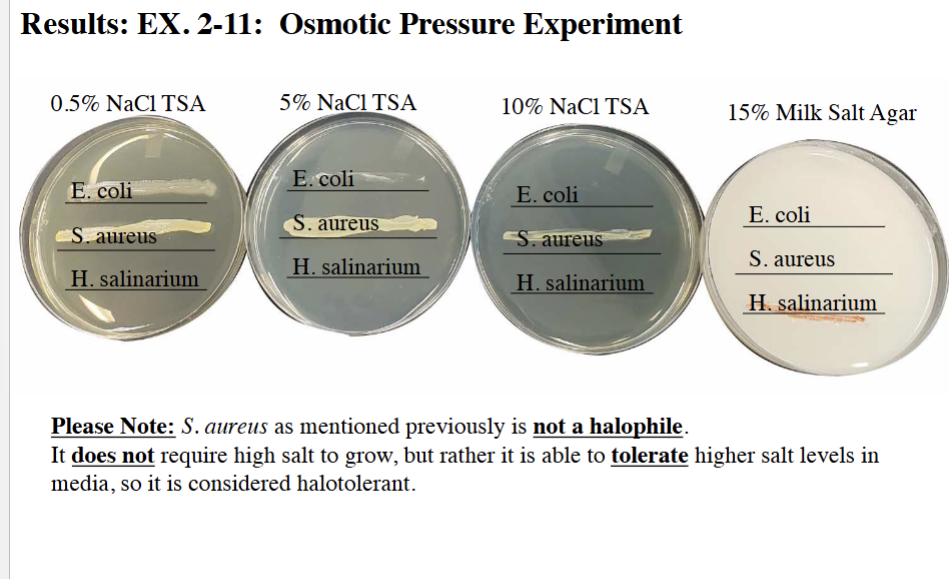
<p>porbably</p>

MB Lab Quiz 4
1/79
There's no tags or description
Looks like no tags are added yet.
Name | Mastery | Learn | Test | Matching | Spaced | Call with Kai |
|---|
No analytics yet
Send a link to your students to track their progress
80 Terms
6-5 Start
GOOOOD is real god is real god is actaully real im not kidding this time god is real i wouldnt joke about this
Virus vs Bacteria
Virus =
Smaller
Acellular
CANNOT grow on normal media, require hot cell
Lackding celllular machinery
ONLY have DNA/RNA
Can infect prok or euk
Phage/ bacteriophage + name for ecoli phage
Virus that infect bacteria
Coliphage = ecoli bacteria
Lyytic vs lysogenic virus
Lytic virus = VIRULENT
Enters ell, takes over, replicates, lyse for release
Lysogenic = TEMPERATE means phage does not immediately kill host
Enter cell
Integrate into DNA
Cell replicate normally
Eventually virus replicates + lyse cell
VIU
Virus infection unit
Smallest unit causing EFFECT on host
Plaque/ PFU
Zone of lysis/growth inhibiton in a LAWN of bacteria
1 plaque = 1 virus
Assay count efficiency vs electron microscope
NOT as efficient, Why?
Efficiency of infection by virus is NOT 100% so electron microscope is better
Enrichment purpose + teps
Increase number of phage in raw sewage
Combine
Sewage
E.coli = host
DSPB (10x stronger than ordinary TSB, accommodate dilution with sewage water)
Enriches the HOST bacteria for growth, which then increases phage number
DSPB
Is NOT a broth for growth of phage directly
Phage CANNOT grow in the broth alone
Requires host
E.coli acts as HOST and SELECTS for type of virus, that being coliphage
DSPB increases number of E.coli which indirectly increases phages in broth
Filtration purpose
Seperate E.coli from phage
Filtration steps + pore size + type of filter apparatus
Use 0.2 MCM filter, allows virus to pass but NOT bacteria
Sample MUST be centrifuged prior to filtration
Removes cellular debris = no clogging
Nalgene filtration apparatus
only need 2ml
Seeding purpose
Plate dilution of filtrate WITH E.coli to see phage evidence and find concentration of phage in original filtrate
Seeding steps + type of agar
Use SOFT NUTRIENT AGAR
Liquefied in water bath so that they can be spread evenly on plate
Add diluted filtrate + E.coli to agar tube and ROLL BETWEEN HANDS
Pour contents evenly in prewarmed TSA plate
Why prewarmed TSA?
Prevents solidification as soon as it hits plate, allows agar to flow over entire surface
How long for plaques to appear on plate
2-2.5 hours of incubation
IF YOU WAIT LONGER, plaques will merge together = difficult to count them individually
know?

Oxygen requirments 2-6,2-7,2-8 START
Aerotolerance
Organism ability or lack of ability to grow in presence of oxygen
Aerobes
REQUIRE oxygen, use it as final electron acceptor
Facultative anaerobes
Can grow in both BUT prefer oxygen
If oxygen, they can utilize it like normal aerobes
If no oxygen, can obtain from alternate source, like nitrate
Anaerobes
CANNOT grow with oxygen
Oxygen = inhibitory or lethal to bacteria
Lack enzymes to deal with harmful products of oxygen metabolism
Microaerophiles
Require free oxygen, ONLY in limited amounts
Think micro = small amount of oxygen cool!
Capnophiles
Microaerophile that require ELEVATED levels of CO2 to survive
Simple enough
TSA Deep + oxygen status
Solid agar
Removed oxygen from atuoclaving diffuses back into media as solidifies
Creates oxygen gradient, MORE at top (aerobic) less or none at bottom (anaerobic)
TSA shake
Same preparation as TSA deep but kept as liquid in warm water bath
After inoculation, tube is GENTLY rolled between palms to disperse bacteria
THEN allow to solidify
As media solidifies, oxygen gradient is created with bacteria
FTM (stand for and what it contains)
Fluid thioglycolate medium
Basic medium that contains sodium thioglycolalte, Lcystinine, reazurin, agar, gelatin
OXYGEn gradient formed during media cooling
Thioglycolate + L-cystine function
Reducing agents
Reduce oxygen present in media to water
Resazurin
Dye used as oxygen indicator
With oxygen becomes = PINK
This is why the top is PINK, and fades out
Absence of oxygen = YELLOWISH (natural color media)
PINK is hard to see following inoculation and bacterial growth
Agar + gelatin
Small amounts
Helps to localize the organisms as they grow
TSA plates + GasPak purpose
GasPak- used to create an anaerobic enviornment
Gas generator sachet (3 things it contains and functions)
BBP -peruvians
Contains sodium borohydride + sodium bicarbonate
Borohydride
Upon air exposure, sachet becomes activated
Hydrogen from borohydride COMBINES with oxygen with help of palladium to fomr water
Bicarbonte
Produces CO2 gas
Contains palladium - IMPORTANT
Catalyst between hydrogen and oxygen
Anaerobic indicator strip
Paper strip with RESAZURIN
Pink with oxygen, cololress/white without oxygen
3 bacteria used
Clostridium sporogeneses - white/cream
Endospore former
Can contaminate imporperly canned food / stored
Escherichia coli - white/cream
Found all over + in intestines
Can produce endotoxins = UTIS, food poisning, etc.
Micrococcus luteus - yellow due to CAROTENOID PIGMENTS
Found in soil, dust, water, human skin
Sign of improper decomination in labs
Oxygen growth status of 3 bacteria
Clostridium sporogeneses = OBLIGATE ANAEROBE (no oxygen)
Will grow in lower part
E.coli = FACULATIVE ANAEROBE (better with oxygen)
Will grow all over, but HEAVIER at top
M. luteus (Obligate AEROBE) = REQUITES OXYGEN
Only grow at top
TSA plate results
LOOK AND KNOW, it goes with other stuff
Temperature 2-9 start
Temperature =
ONE OF THE MOST IMPORTANT FACTORS FOR BACTERIAL ENZYME ACTIVITY
Cardinal temperatures
Range of temps that enzymes can function at
Minimum vs maximum vs optimum cardinal temp
Minimum = lowest, lower will = INACTIVE
Max = highest, higher = inactive + destructure
Optimum = growth rate is highest, enzymes at max speed
Psychrophiles CHRO
0-20 (CANNOT grow above 20)
Common in arctic + antartic akak PERMANENTLY COLD TEMPS
Mesophile
15-40
Human bacterial pathogens fall in this category
WHY? because human body temp is around 37
MESO = middle
Thermophile
Above 40
Typically in hot springs
Extreme thermophile
65-110
Optimum of around 80
Bacillus Stearothermophilus KNOW SPELLING
Cream color
Endospore forming
Thermophile
Expeirment = 50 + 65
E. coli
Cream colored
Mesophile
Often incubated at 37, lives inside human
Experiment = 25-37
Serratia marescens
at 25-30 = Red pigment prodigiosin
37 = growth but CREAM COLORED like ecoli
Experiment = 25-37
2-11 OSMOTIC start
hurray? you said now its gone away, brought back we can try things over, as if there wasnt ever pain, SWEETER this time will be sweeter, i can be much sweeter, now back inside your cage
Water
Principal component of cytoplasm + source of electrons + hydrogen ions
ALSO, required for cellular turgor pressure
Turgor Pressure
Counter pressure required to maintain integrity of cell shape and microorganism
ESSENTIALLY, the outward force pushing out that retains shape
2 components of turgor pressure
High potassium or sodium ions concentration- promotes inward diffusion of water
Compatible solutes - composed of amino acids to help maintain turgor pressure
Bacteria in saline environment + turgor rpessure
Saline/ high salt environment = CONSTANT effort to maintain turgor pressure as cell is fighting against shrinking
Osmosis
Movement of water from region of high concentration to low concentration ACROSS a semipermeable membrane
Hypotonic vs isotonic vs hypertonic
Hypo
Environment has low solute = constant movement water inward
Swelling/ burst
Isotonic
Equal solute concentration
Movement in and out = equal
Hypertonic
Environment has HIGH solute = constant movement out
Shrinkage of membrane = plasmolysis
Halotolerant
TOLERATE high salt, but do not REQUIRE
If it can grow in media with lower salt then it does not REQUIRE and thus is not a halophile
Halophile
Salt loving = REQUIRE NaCl
NaCl must be 3% or higher
MUST HV
Extreme halophile
15-25% NaCl
WIll NOT survive in low solute env
Osmophile
Require high concentrations of ORGANIC SOLUTE
Like sugar
Xerophile
Grow in LOW WATER ACTIVITY env
This means DRY enviornment, or enveiornments where there is littel available salts
What dose this mean
E.coli
NON-halophile
Cream colored
E. coli = requires STANDARD salt concetnariton, around 0.5%
Halobacterium salinarum
EXTREME halophile
Reddish colored colonies
Found in great salt lake + dead sea = high saline
Utilizes potassium chloride + compatible solutes to reduce
Staphylococcus aureus, RG 2
Halotolerant
RISK GROUP 2, must use biosafety cabinet
Golden color
WHY? Carotenoid pigments
Can grow in 0.5-10% but thats abou tit
Aka DOESNT need ti
Results know percentages and growth
porbably
Oxidation and Fermentation Tests, unkonwn day 3
WOAH
Catalase test
Using slants
Tests for:
CATALASE enzyme = breaks down hydrogen peroxide into water and oxygen
Reagent
Hydrogen peroxide 3% to slant
Positive = bubbles
Negative = no bubbles
Sugar fermentation tubes/ Durham tubes
Liquid TSB broths
Tests for:
Fermentation of sugars (gluc, lac, mannitol)
Reagent:
Phenol red = pH indicator
Red over 7, yellow under 7
Inverted/durham tube = detects gas w/ fermetnaiton
Bubbles will appear if gas produced
DONT VORTEX, will make bubbles
Results:
Positive ferment = yellow
Positive gas production = bubble
Negative ferment = red
Negative gas production = no bubble
What is the nitratase test really asking (2 questions)
1. Does the organism have nitratase (nitrate reductase)?
This enzyme converts nitrate (NO₃⁻) → nitrite (NO₂⁻).
2. If nitrite is NOT present, did the organism…
reduce nitrate even further (to ammonia, nitrogen gas, etc.)
ORnot reduce nitrate at all?
Why add zinc in nitratase test
Its possible that the organism reduced nitrate PAST nitrite
OR it didnt reduce nitrate at all (aka doesnt have nitratase)
SO
Zinc chemically reduces nitrate to nitrite (acting like enzyme
SO SO:
If it turns red after zinc = NO nitratase, because nitratase would have done it
Nitratase test
Test for:
Nitrate presence as electron acceptor in anaerobic respiration
AND Nitratase presence, converts nitrate to nitrite
Reagents - SA DAN
Sulfanilic acid
Dimethyl - a - naphthylamine
Both of these detect NITRITE
If present = turn red
Not present = no red
Steps
Add 10-15 of both to tubes
No color change = add zinc
Results
SO:
Red no zinc (red initial) = Nitratase positive
Means nitrate turned to nitrite via nitratase
Red with zinc = Nitratase negative
Because zinc had to do the job
No color w/ zinc = Nitratase positive
Because it means nitratase reduced BEYOND nitrite
Methyl Red test (MR)
Tests for:
Production of acid upon glucose fermentation
Indicator that organism is mixed acid fermenter
Reagent + result
Methyl red = pH indicator
Red for pH under 5 (positive test)
Yellow for pH over 5 (negative test)
MUST vortex
Voges Proskauer Test (VP)
Tests for:
Alcohol production FOLLOWING glucose fermentation
Detects ACETOIN = 2-3 butanediol precursor
does NOT detect ethanol or 2-3 butanediol
Reagents AN KOH
Alpha naphthol
KOH (potassium hydroxide)
Positive
Red color change
Negative = yellow brown color
KIA/ Kligler’s Iron Agar slant
Tests for:
Fermentation of glucose and lactose
Presence of H2S/ hydrogen sulfide
Gas produciton
Reagents (already in media)
Phenol red = pH indicator
Red over 7
Yellow under 7
Different sugar concentrations = color change distribution
Iron salt
Tests for H2S production
KIA results
Positive
Lactose ferment = yellow THROUGHOUT tube
Glucose ferment = RED SLANT, but YELLOW BOTTOM
H2S = dark precipitate of iron sulfide (Black color in media)
Gas = crack sin media or bubble at bottom

Glucose and lactose in KIA
Lactose on TOP
GLucose on BOTTOM
Thas why bottom turns yellow if glucose positive
Yellow = more acidic remember
So lactose + glucose ferment = yellow all throughout
OK? is this making sense
Neithe r= red/pink throughout
Miscellaneous tests (day 4 unknown) start
ALL SLANTS SHOULD BE + SIM DEEP SHOULD BE
Slant = Streaked and stabbed
SIM deep = SINGLE stap enter and exit through same, why? because of motility
All incubate at 37
Simmons Citrate test
Tests for:
Utilization of citrate as SOLE CARBON SOURCE
Reagents
NONE
Positive = Prussian blue
Negative = green color
Phenylalanine Deamination Test
Test for:
Presence of PHENYLALANSE, breaks down phenylalanine into phenylpyruvic acid/ PPA
Reagent
10% ferric chloride, detects PPA via color change
Positive = deep green color change
Negative = yellow color (of reagent)
SIM Media Deep
Tests for:
SIM
S = H2S/hydrogen SULFIDE (s) production
I = Indole presence
M = motility
Reagents
Chloroform = solubilize media (makes it PERMABLE to Kovac’s reagent)
Kovac’s reagent
Also contains
TTC (2,3,5 triphenyl tetrazolium chloride)
SIM breakdown + TTC
S:
Iron salts in media = test H2S
I
Chloroform + Kovac reagent test for INDOLE (more so TRYPTOPHANASE)
Indole = due to TRYPTOPHANASE enzyme which converts tryptophan into indole + pyruvic acid
M/ motility
Use SEMI SOLID MEDIA + single inoculation point
Less agar = allows for shape but also motile organism to move
TTC
Colorless and soluble when oxidized = no movement
Red when reduced
SIM Results
Positive
H2s production = dark precipitate of iron sulfide
Tryptophanase/indole = red ring at top
Motility = growth radiating from line of inoculation
OUTWARD
and cloudy in tube
Negative
OPPOSITE OF ALL OF THESE
